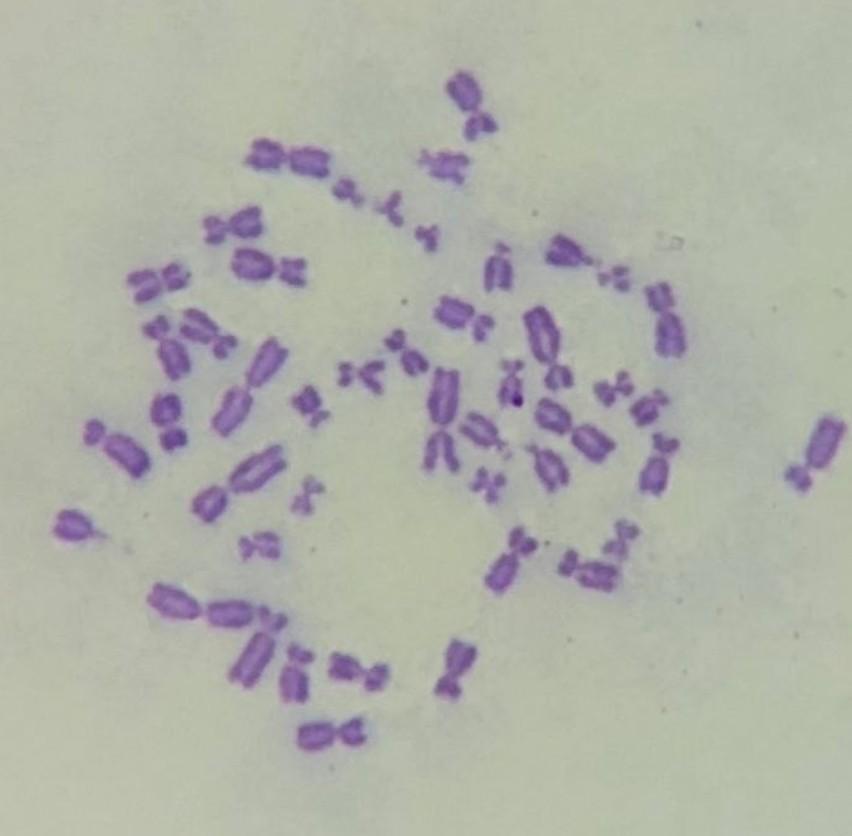

Ответы
Ответ дал:
0
Ответ:
Приблизно 47 хромосом
Объяснение:
Людський каріотип становить 46 хромосом:
22А+Х та 22А+У
Вас заинтересует
2 года назад
2 года назад
2 года назад
2 года назад
3 года назад
3 года назад
9 лет назад
9 лет назад